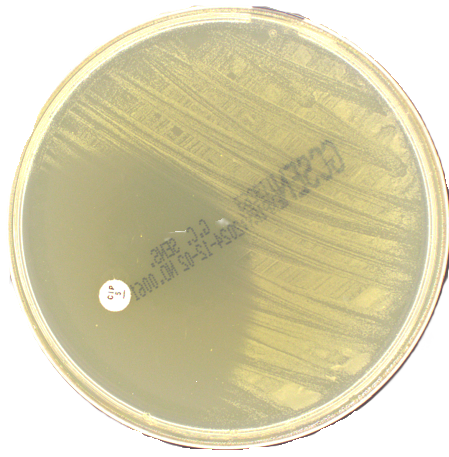

ie
Description: GC media is used in Antimicrobial susceptibility testing (AST) of Neisseria gonorrhoeae and other fastidious microorganisms
Catalogue No: W11074
Product Type: 90mm Petri Dish
Unit Size: 10
Storage Temp: 2-10°C
pH Value: 7.3 +/- 0.2
Growth Promotion:
Neisseria Gonorrhoeae ATCC® 49226 Growth
N.B. Some products may be subject to minimum order quantity